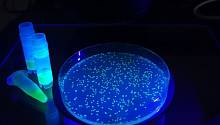

Фотография для шапки блога:Если нужно, измените границы. Выбранная область будет представлена в шапке вашей страницы.

Друзья. Если вы решили зарегистрироваться в нашем Мегаполисе, то вам придется немного потрудиться и ответить на несколько вопросов. И даже постараться вставить две собственные фотки. А я понимаю, что это не просто. Ох как не просто...
Один мой приятель позвонил мне по этому поводу и стал ругаться.
Типа: «Ну зачем все так сложно? Может тебе еще и размер ботинок написать?!» На что я ему ответил: «Чтобы просто почитать, не надо регистрироваться. Заходи и читай. Мы всем рады.
А вот если после прочтения ты вдруг решишь со мной жестко поспорить, то вот тут-то надо оставить о себе немного информации. Может, даже размер ботинка. Чтобы я понимал, с кем имею дело, когда буду принимать решение - спорить ли с тобой вообще…»
Это, конечно, шутка. Но я хотел бы вам сказать, что мы не строим копию Твиттера или ВКонтакте. Они круче... Мы создаем для себя и для вас журнал. Научно-популярный журнал. Который в современных условиях должен не только писать, но и говорить, отвечать, спорить, ругаться и т.д., оставаясь при этом журналом.
Мы создаем площадку для тех, у кого есть что рассказать другим, и они не боятся это сделать. Поэтому давайте без обид. Я буду вам благодарен, если вы решитесь на этот шаг. Удачи...